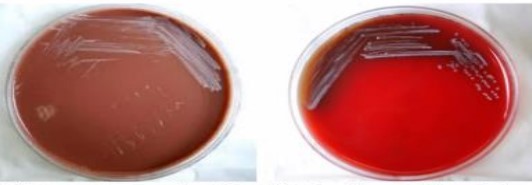

Abstract:
Background: Brucellosis is caused by Gram-negative coccobacilli-shaped bacteria of the genus Brucella. The transmission of the disease occurs through the ingestion of undercooked meat or unpasteurized dairy products, through the inhalation of aerosols by slaughterhouse and meatpacking plant employees and laboratory professionals.
Case Report:
• 40 year male patient,hailing from North Eastern India;c/o pain abdomen since 2 months and c/o upper abdomen swelling since 1 month.Pain abdomen: insidious onset,progressive,dull aching pain a/w intermittent nausea,fever.Upper abdomen swelling:insidious onset,progressive,warm and painful but not associated with any discharge. No similar complaints in past; Known diabetic since 1 year on medication but stopped taking medicines since 3 months.Not a known hypertensive,CKD,CLD or other chronic illness.No past history of tuberculosis;no contact history of tuberculosis.Takes mixed diet;occasional alcoholic;occasional smoker
• Patient was conscious,coherent,cooperative and normal vitals
• LOCAL EXAM: A soft,globular swelling of 9cm*12 cm in left lower chest area,warm,non-tender,not fixed to skin and systemic examination CVS-S1,S2 heard,No murmurs;RS-B/L NVBS+;P/A-hepatomegaly,2 cm below right coastal margin,Splenomegaly-tender,2cm below left coastal margin;CNS-NFND
Investigations showed LAB VALUES: Hb-12,WBC-9300(N-70%),PLATELETS-2.9 LAKHS;LFT AND RFT: NORMAL;CXR PA – normal. So based on the above history and investigation patient was suspected to be a case of tuberculosis or malignancy and they advised for further work up at higher center.
USG W/A and HRUSG of the swelling and USG W/A showed multiple splenic abscess with largest measuring 14*16 mm and HRUSG revealed 12*15 cm abscess with multiple internal septations.
Diagnosis:
• Pus from soft tissue abscess was drained and sent for :-
• Gram stain- Multiple gram negative bacilli seen
• ZN STAIN,fungal stain- negative
• C/S- No growth
• CB-NAAT-neg
• MGIT C/S-no growth
NGS- Brucella abortus
Management:
• Patient was diagnosed as Brucellosis and treatment was initiated with INJ.DOXYCYCLINE AND TAB.RIFAMPICIN 600mg was given for 3months and in between patient complained of headache and nausea and hence MRI BRAIN was done which was entirely normal and the abscess was drained both USG guided and surgical drainage done and about 100ml of pus was removed and then recovered
Conclusion: In the literature, the possibility of performing molecular biology tests to diagnose brucellosis is discussed, as they can aid in performing a quick diagnosis; only a few hours are needed, with high sensitivity and specificity.
Health and veterinary professionals must be instructed on the use of personal protective equipment when handling viscera and animal parts.
FIG 1: BLOOD CULTURE SHOWING GROWTH OF BRUCELLA
FIG 2: GRAM STAIN

FIG 3:RADIOLOGY OF LIVER ABSCESS

Biography:
Post-Doctoral Trainee in Infectious Diseases with strong clinical, academic, and research experience in managing complex infections, including immunocompromised hosts. Proven track record in national and international presentations, publications, and awards. Special interest in antimicrobial resistance, mycology, and emerging infections.